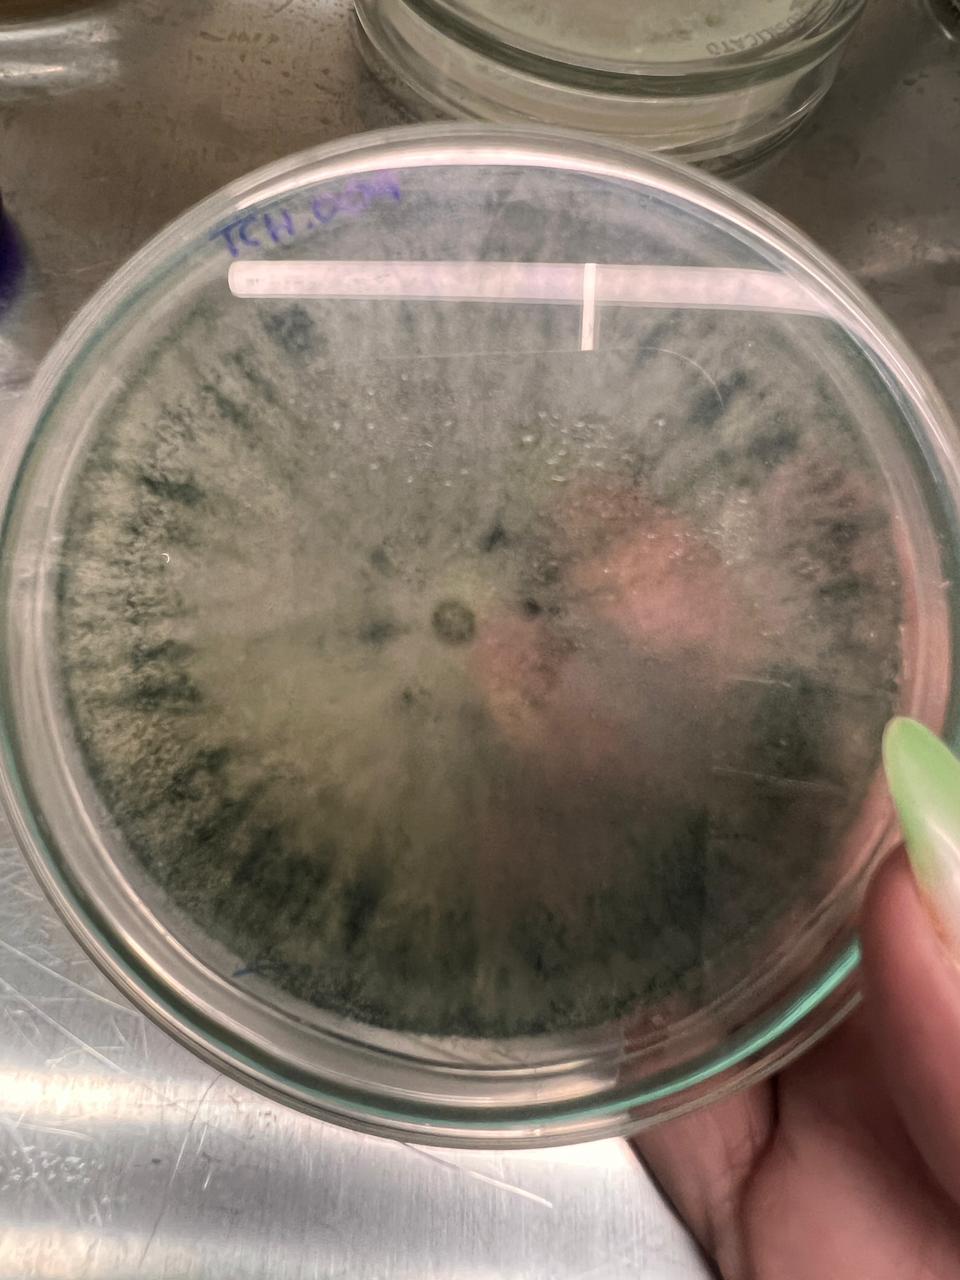

La Universidad Provincial de Laguna Blanca celebra con orgullo la graduación de Pamela Evelin Silvero, quien se convirtió en la primera egresada de la carrera Enfermería Universitaria de nuestra casa de estudios. Su logro académico representa un hito institucional, un motivo de alegría y un orgullo para toda la comunidad formoseña.
Últimas Noticias
Tras rendir sus exámenes finales el 19 de diciembre, 28 estudiantes finalizaron sus carreras y se convirtieron en nuevos egresados y egresadas de la Universidad Provincial de Laguna Blanca.
La Universidad Provincial de Laguna Blanca (UPLaB) celebra un nuevo logro académico con la graduación de 10 estudiantes de la carrera de Enfermería Universitaria, quienes culminaron su formación y se incorporan como nuevos profesionales comprometidos con el cuidado de la salud y el bienestar de la comunidad.
El pasado 6 de noviembre, en el laboratorio de la Universidad Provincial de Laguna Blanca (UPLaB), se desarrolló una intensa jornada práctica en el marco del Curso de Posgrado “Bioinsumos: Herramientas microbiológicas y biotecnológicas aplicadas a la producción vegetal”.
La Segunda Jornada de Investigación de la Universidad Provincial de Laguna Blanca (UPLaB) se llevó a cabo el pasado 14 de noviembre y constituyó un valioso espacio de intercambio, reflexión y difusión del conocimiento, que reunió a estudiantes, graduados, docentes invitados y docentes investigadores de la institución.
- Noticias
- Visto: 555
La UPLaB continúa la Promoción de Carreras 2026 en comunidades del oeste provincial
En el marco de la Promoción de Carreras 2026, la Universidad Provincial de Laguna Blanca (UPLaB), siguiendo los lineamientos del Modelo Formoseño y reafirmando su compromiso con una educación pública, inclusiva, con equidad territorial y de calidad, recorrió distintas localidades de la provincia para acercar su oferta académica a todas y todos los formoseños.